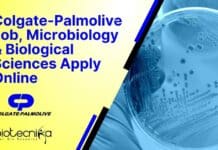
Colgate-Palmolive Job, Microbiology & Biological Sciences Apply Online Colgate-Palmolive Job

CSIR NET June 2022 Answer Key Released + Download QP + Ans Key +...
CSIR NET June 2022 Answer Key
And the wait is finally over. CSIR NET June 2022 Answer Key has been released per the latest update...
Biotecnika Times Newsletter 30.09.2022 Govt HPSSC Jobs, CSIR-IGIB, NIFTEM, Reliance Hiring
Biotecnika Times Newsletter 30.09.2022 Govt HPSSC Jobs, CSIR-IGIB, NIFTEM, Reliance Hiring
Govt HPSSC Food Safety Officer Recruitment – Online Application Portal OPEN
Govt HPSSC Food Safety...
NIANP Biotech, Biochem, Mol Bio, Genetics Jobs, Applications Invited
NIANP Biotech, Biochem, Mol Bio, Genetics Jobs, Applications Invited
NIANP Biotech, Biochem, Mol Bio, Genetics Jobs, Applications Invited. Bengaluru jobs. NIANP Bengaluru vacancies. MSc SRF/RA...
NIRRCH Biological Sciences Project Assistant Recruitment, Apply Online
NIRRCH Biological Sciences Project Assistant Recruitment, Apply Online
NIRRCH Biological Sciences Project Assistant Recruitment, Apply Online. NIRRH recruitment for Project Assistant vacancy. NIRRCH National Institute...
AIIMS New Delhi JRF Job – MSc Life Sciences Candidates Attend Walk-In
AIIMS New Delhi Vacancy JRF - MSc Life Sciences Candidates Attend Walk-In
AIIMS New Delhi Vacancy JRF - MSc Life Sciences Candidates Attend Walk-In. MSc...
THSTI MSc Life Sciences Technical Officer Jobs, Applications Invited
THSTI Vacancies 2022 For Life Sciences, Applications Invited
THSTI Vacancies 2022 For Life Sciences, Applications Invited. MSc Life Sciences jobs. Interested and eligible applicants can...
IQVIA BSc Life Sciences Clinical Process Associate Job Opening
IQVIA BSc Vacancy Available - Life Sciences Apply Online
IQVIA BSc Vacancy Available - Life Sciences Apply Online. Interested and eligible applicants can check out...
NIFTEM Food Tech, Biotech, Food Science RA Job Opening, Applications Invited
NIFTEM Food Tech, Biotech, Food Science RA Job Opening, Applications Invited
NIFTEM Food Tech, Biotech, Food Science RA Job Opening, Applications Invited. PhD Biotech, Food...
Colgate-Palmolive Job, Microbiology & Biological Sciences Apply Online
Colgate-Palmolive Job, Microbiology & Biological Sciences Apply Online
Colgate-Palmolive Job, Microbiology & Biological Sciences Apply Online. MSc Biological Sciences & Microbiology Jobs. Interested and eligible...
Reliance Industries Research Scientist For MSc & PhD Biotech, Biochem, Biophysics
Reliance Industries Research Scientist For MSc & PhD Biotech, Biochem, Biophysics
Reliance Industries Research Scientist For MSc & PhD Biotech, Biochem, Biophysics. Interested and eligible...
NIPER Hyderabad Biotech, Biochem & Mol Bio Project Job Opening
NIPER Hyderabad Biotech, Biochem & Mol Bio Project Job Opening
NIPER Hyderabad Biotech, Biochem & Mol Bio Project Job Opening. National Institute of Pharmaceutical Education...
CSIR-IGIB Biotech, Biochem, Immunology, Life Sciences & Microbiology Project Jobs
IGIB Research Vacancies 2022 For Life Sciences, Biotech - Apply Online
IGIB Research Vacancies 2022 For Life Sciences, Biotech - Apply Online. IGIB Research Openings...
Biotecnika Times Newsletter 29.09.2022 TIFR GS2023 Exam Alert, Freshers Interns, Govt NIFTEM, KAPL Jobs
Biotecnika Times Newsletter 29.09.2022 TIFR GS2023 Exam Alert
TIFR GS2023 Exam Alert For MSc / Int.PhD / PhD Admissions
TIFR GS2023 Exam Alert For MSc /...
Freshers Project Intern Jobs For BSc Biotech & Microbiology at ICT Mumbai
Freshers Project Intern Jobs For BSc Biotech & Microbiology at ICT Mumbai
Freshers Project Intern Jobs For BSc Biotech & Microbiology at ICT Mumbai. BSc...
NIFTEM Food Science & Food Tech JRF Recruitment, Applications Invited
NIFTEM JRF Job 2022 For For Food Tech, Food Science
NIFTEM JRF Job 2022 For For Food Tech, Food Science. MSc & MTech Food Technology,...